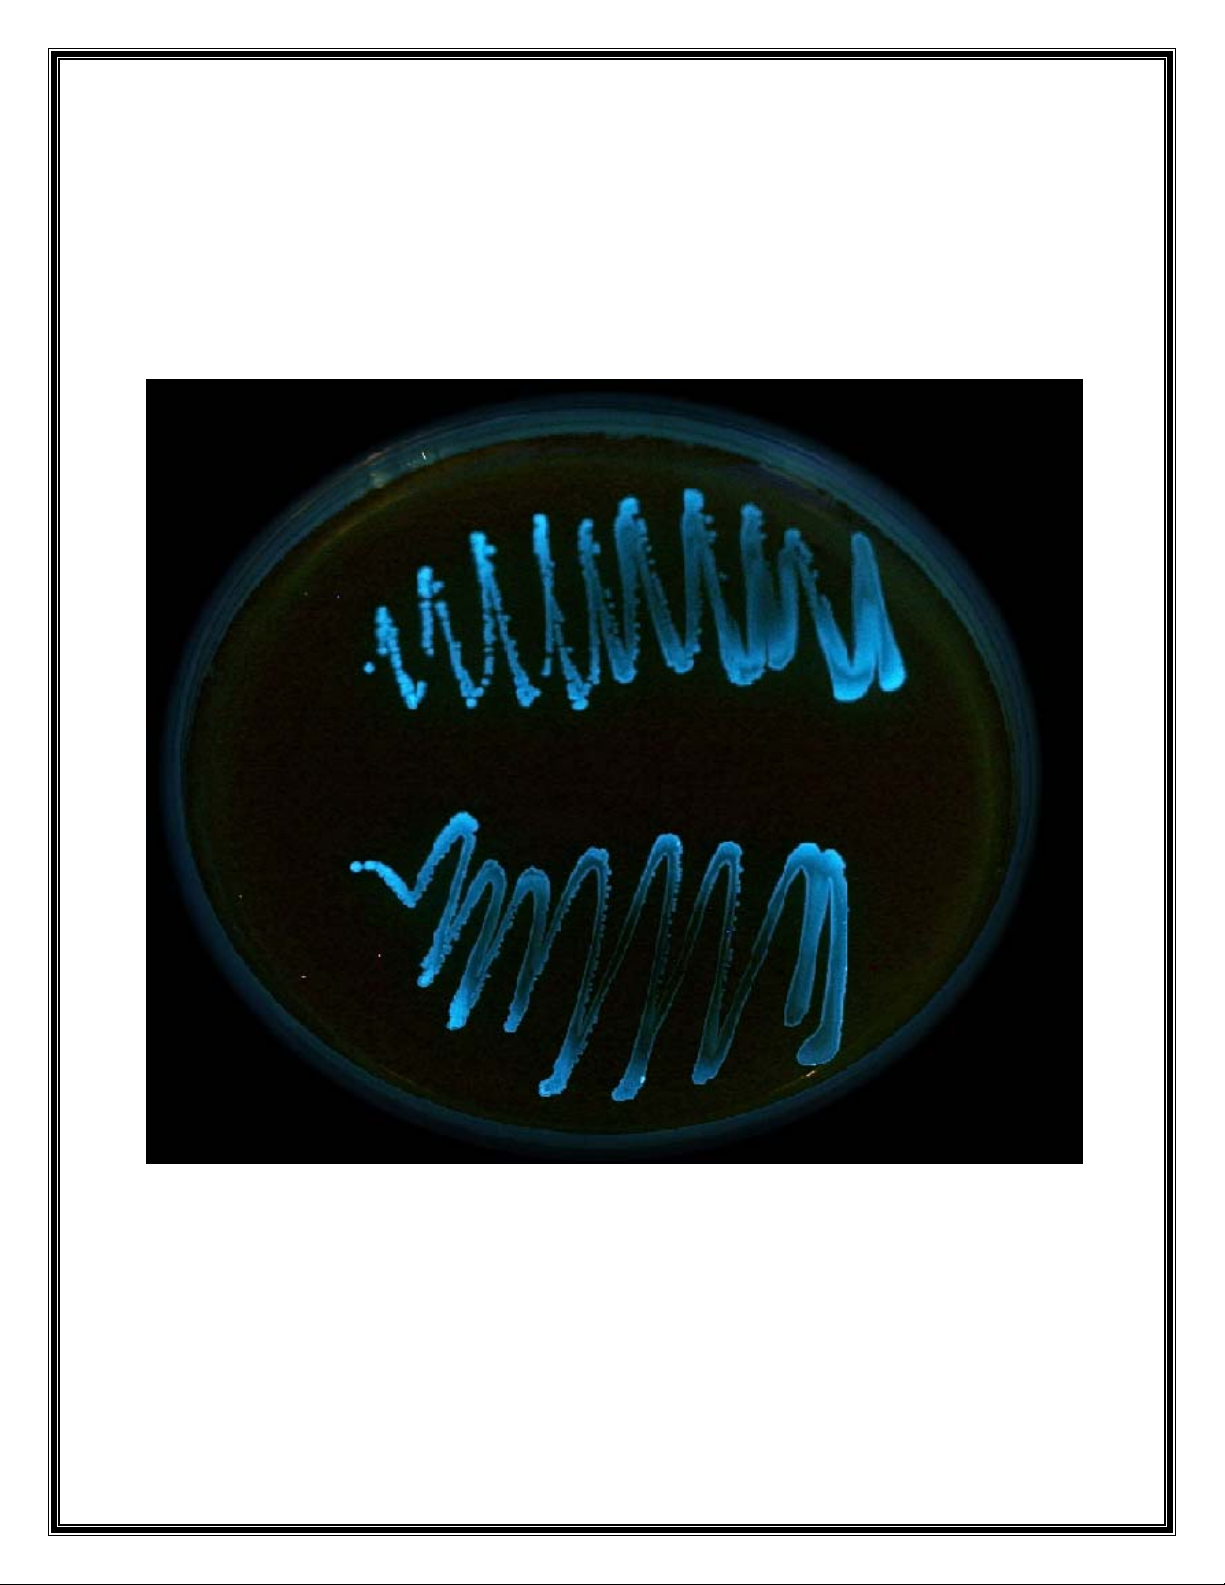

Khả năng ức chế quá trình phát sáng sinh
học ở Vibrio harveyi bởi enzyme AHL-
lactonase tái tổ hợp
Trong vòng ba thập kỷ trở lại đây, các nhà khoa học đã khám phá ra quá trình
“quorum sensing” như là một quá trình giao tiếp ở thế giới vi khuẩn, trong đó việc
tổng hợp và dò tìm một loại phân tử tín hiệu thực hiện điều hòa việc biểu hiện gen.
Quá trình này được chứng minh là có liên quan trực tiếp đến sự biểu hiện gen mã
hóa các yếu tố độc lực ở một số loài vi khuẩn gây bệnh trên động vật thủy sản, ví
dụ như Vibrio harveyi, V. parahaemolyticus, Aeromonas hydrophila, Edwardsiella

tarda, Edw. ictaluri. Hệ thống quorum sensing ở Vibrio harveyi bao gồm ba đường
dẫn khác nhau đều ảnh hưởng trực tiếp đến quá trình phát sáng sinh học ở loài vi
khuẩn này. Trong đó đường dẫn thứ nhất được điều tiết bởi phân tử AHL (N-acyl
homoserine lactone), một loại phân tử tín hiệu quorum sensing rất phổ biến ở nhóm
vi khuẩn Gram âm.
AHL-lactonase là một trong hai loại enzyme có khả năng phân hủy phân tử AHL.
Enzyme này được mã hóa bởi gen aiiA hiện diện ở các loài vi khuẩn thuộc nhóm
Bacillus spp. Có khá nhiều nghiên cứu trên thế giới trong việc ứng dụng enzyme
AHL-lactonase tái tổ hợp như là một biện pháp kiểm soát sinh học đối với các
bệnh trên cây trồng có liên quan đến quá trình tiết ra phân tử AHL. Trong lĩnh vực
nuôi trồng thủy sản chỉ mới có hai nghiên cứu được công bố gần đây trong việc sử
dụng enzyme AHL-lactonase tái tổ hợp để kiểm soát bệnh do Aeromonas
hydrophila gây ra trên cá chép (Chen và ctv., 2010; Cao và ctv., 2012).
Trong nghiên cứu này (nghiên cứu được tài trợ bởi Quỹ phát triển khoa học và
công nghệ quốc gia), enzyme AHL-lactonase tái tổ hợp có nguồn gốc từ gen aiiA
của chủng Bacillus cereus N26.2 phân lập từ môi trường ao nuôi cá tra, được dòng
hóa (clone) và biểu hiện vượt mức ở chủng E. coli BL21(DE3)pLysS. Enzyme
AHL-lactonase tái tổ hợp được khảo sát khả năng phân hủy phân tử AHL có liên
quan đến độc lực ở V. harveyi và Edw. ictaluri, với mục tiêu lâu dài là nhằm ứng
dụng enzyme AHL-lactonase tái tổ hợp trong việc kiểm soát bệnh do hai loài vi
khuẩn này gây ra trên tôm sú và cá tra.
Trong phạm vi bài báo này, chúng tôi trình bày một số kết quả nghiên cứu trong
việc khảo sát hoạt tính phân hủy phân tử AHL, thông qua khả năng ức chế quá
trình phát sáng sinh học ở vi khuẩn V. harveyi. Hai chủng V. harveyi được sử
dụng: chủng hoang dại BB120 hiện diện cả ba đường dẫn quorum sensing, và
chủng đột biến JMH606 chỉ hiện diện đường dẫn liên quan đến phân tử AHL. Các
chủng V. harveyi được nuôi cấy lắc qua đêm trong môi trường Marine Broth, cho
đến khi OD600 đạt giá trị khoảng 1,0 thì tiếp tục được pha loãng 1/5000 trong môi
trường Marine Broth và phân bổ vào các giếng của đĩa nhựa 96 giếng, với thể tích
100 µl/giếng. Enzyme AHL-lactonase tái tổ hợp được bổ sung vào giếng ở ba nồng
độ (5 µg/ml, 15 µg/ml và 25 µg/ml, 6 lần lập lại/nồng độ). Cường độ phát sáng
(luminescence intensity, LI) của các chủng V. harveyi ở nghiệm thức đối chứng
(không bổ sung enzyme) và ở các nghiệm thức có bổ sung enzyme AHL-lactonase
tái tổ hợp, được đo bằng máy quang phổ Multireader apparatus Infinite M200 liên
tục trong 6 giờ, với khoảng cách là 1 giờ.
Kết quả ở cho thấy pha log của đường cong tăng trưởng của V. harveyi bắt đầu

khoảng sau 4 giờ sau khi nuôi cấy. Việc bổ sung enzyme AHL-lactonase tái tổ hợp
ở các nồng độ khác nhau đã không ảnh hưởng đến tốc độ tăng trưởng của V.
harveyi, thể hiện qua giá trị OD600 không có sự khác biệt theo thời gian ở các
nghiệm thức khác nhau.
Tuy nhiên, khi đánh giá về cường độ phát sáng thì cho kết quả khác biệt giữa các
nghiệm thức. Cường độ phát sáng của chủng hoang dại BB120 đã bị suy giảm một
cách có ý nghĩa thống kê (p < 0,05) ngay ở thời điểm sau 2 giờ, khi enzyme AHL-
lactonase tái tổ hợp được bổ sung ở nồng độ 15 µg/ml hoặc 25 µg/ml (Đồ thị 2A).
Tương tự, cường độ phát sáng của chủng JMH606 cũng bị ức chế có ý nghĩa thống
kê (p < 0,05) ở cùng nồng độ của enzyme AHL-lactonase tái tổ hợp, nhưng chậm
hơn 1 giờ. Ngoài ra, khả năng ức chế của nồng độ 25 µg/ml có khác biệt có ý nghĩa
thống kê so với nồng độ 15 µg/ml.
Qua các kết quả thí nghiệm đã trình bày, cho thấy enzyme AHL-lactonase tái tổ
hợp có nguồn gốc từ gen aiiA của chủng Bacillus cereus N26.2, đã có khả năng ức
chế quá trình phát sáng sinh học có liên quan đến độc lực ở loài vi khuẩn gây bệnh
Vibrio harveyi. Kết quả này mở ra hướng nghiên cứu sử dụng enzyme AHL-
lactonase tái tổ hợp như là liệu pháp sinh học trong việc kiểm soát bệnh do V.
harveyi gây ra trên động vật thủy sản, cũng như khả năng mở rộng hướng ứng
dụng đối với các loài vi khuẩn gây bệnh khác trong nuôi trồng thủy sản.
Nguồn: Nguyễn Thị Ngọc Tĩnh. 2012. Khả năng ức chế quá trình phát sáng sinh
học ở Vibrio harveyi bởi enzyme AHL-lactonase tái tổ hợp. Viện Nghiên cứu
NTTS II.

